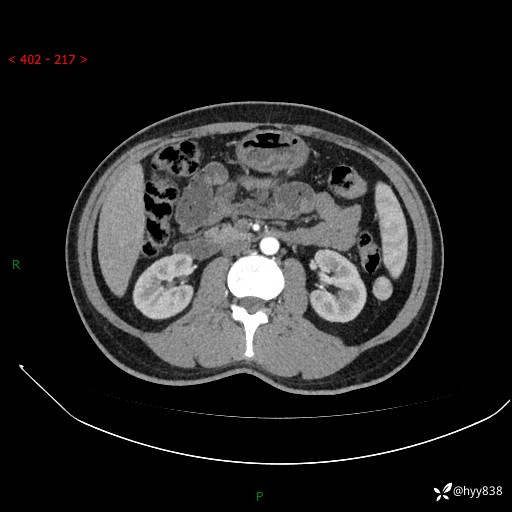
img
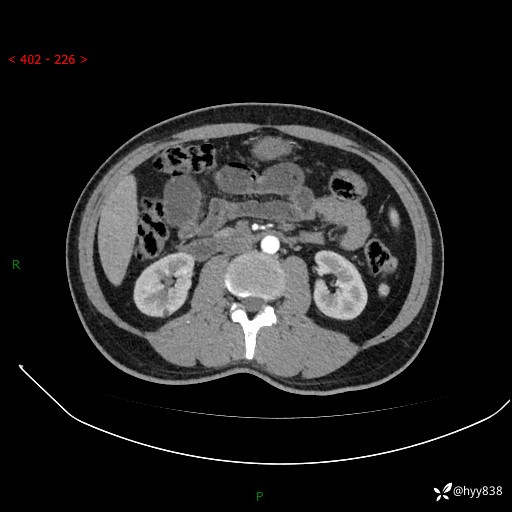
img
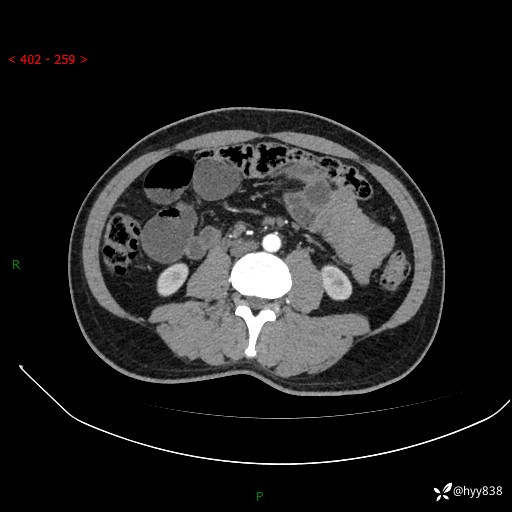
img

年轻男性,腹痛5月余。除了肠梗阻,你还能看到什么---结果公布~
胡志勇HZY 达人已点赞病例信息
性别:男
年龄:32岁
主诉:腹痛5月余。
现病史:患者于5月前无明显诱因开始出现腹痛,上明显,为间断性胀痛不适,无畏寒发热,无心慌气促等特殊不适,遂来我院。我院门诊遂以“腹痛原因待查”收入我科。 起病以来,患者精神、饮食、睡眠欠佳,大小便正常。体力体重无明显变化。
腹部CT增强扫描(动脉期+静脉期)


























胡志勇HZY 达人已点赞病例信息
性别:男
年龄:32岁
主诉:腹痛5月余。
现病史:患者于5月前无明显诱因开始出现腹痛,上明显,为间断性胀痛不适,无畏寒发热,无心慌气促等特殊不适,遂来我院。我院门诊遂以“腹痛原因待查”收入我科。 起病以来,患者精神、饮食、睡眠欠佳,大小便正常。体力体重无明显变化。
腹部CT增强扫描(动脉期+静脉期)